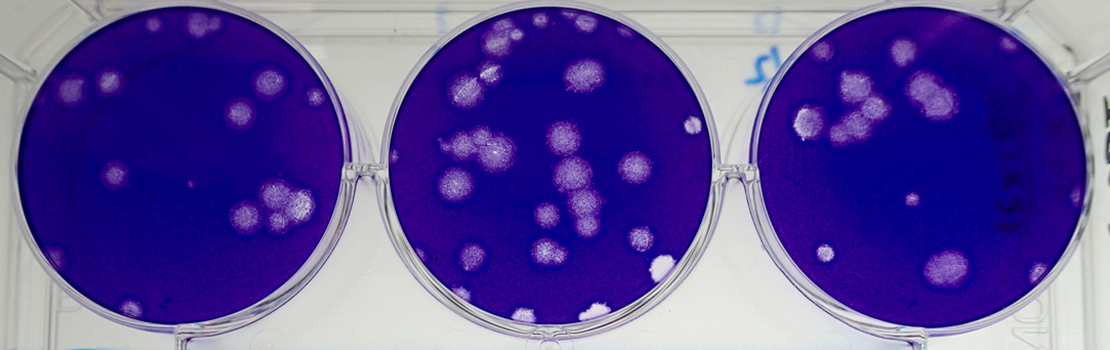

口蹄疫新的抗病毒阻塞超传播器轨迹
牛院国家动物卫生院的Tatsuki Nishi大夫和Kazuki Morioka大夫农粮研究组织测试口蹄疫病毒(FMDV)养猪抗病毒毒药(T-1105)可能防止突发传播,因为它抑制猪产生病毒粒子猪目前被认为是牛传染疾病的超级传播者,因此战略部署T-1105可能完全改变管理这一昂贵威胁
任何农区都指口蹄疫(FMD),FMD病毒寄生动物 包括经济上关键牛群牛猪类动物一旦感染后,往往会生成痛苦泡泡,主要在口脚中产生泡泡,并可能永久心脏损伤和虚弱状态
症状令人不快,但或许恐惧来源于该疾病快速易传播动物可以吸入口蹄疫粒子或因接触生病邻里或触摸受感染动物触摸的表面而受感染

口蹄疫与常见感冒和COVID-19相似快速进化RNA病毒,多段传出并在不同时间扩散同COVID-19一样,各国选择独立方法处理该疾病,许多国家投入大量资源成为零FMD如果区域能显示它们没有FMD,这些农场的动物产品可以出售到更多出口市场。
疾病对受感染动物并非常致命, 但病毒传播潜力广广驱使对本地消除FMD投入巨量控制FMD使用的主要策略之一是摧毁可能接触该疾病的动物并限制该地区或甚至整个国家牲畜运动这可能具有经济破坏性 — — 因此,极需新工具来阻止暴发并改善动物健康
系统内猪
在口蹄疫世界 并非所有动物都平等现场数据显示养猪场与二级病例数的增加大相联养猪场似乎可成为高产病毒工厂上部浮转消化道从病毒的视角看似乎是一个特别美妙的地方, 特别是高量病毒生成于此受感染动物口腔、鼻孔和哺乳腺都染上恶性损耗和冒泡,并随处投放病毒
猪和他们的亲友常被称为FMDV增压器上头出点问题 加入养猪场 突然间这个区成为严重的病毒热点

疫苗极限
疫苗一直用于FMD战斗非激活FMDV诱发保护豁免病毒类似菌株,但至少需要一周构建受感染动物捕捉FMD后似乎病情减少,但往往新菌株仍能大量在动物宿主内复制,因此受感染动物仍会传染
还有其他问题 大规模疫苗接种策略FMD不幸很难确定哪些动物有抗原(表示动物接触病毒),因为它们接种疫苗,哪些动物可能有抗原,因为它们有病本身表示很难验证任何出口肉类产品实际上无病性, 从而降低肉类产品的价值和农户进入不同市场的机会。
T-1105攻击机器 病毒依赖它复制新机制毒
病毒极难控制相对简单结构利用宿主细胞的能源制造和生殖机制制造更多病毒并发回世界供他们寻找更多宿主简洁性是他们能相对快速进化的原因之一 并持续向宿主展示新面孔

动物免疫系统使用疫苗,日本国家农粮研究组织动物卫生院Tatsuki Nishi博士和Kazuki Morioka博士正在评估一种设计直接干扰病毒机能的化学物。此类复合物被称为“反病毒”,在此例中测试了称为T-1105的有机复合物(3-Hydroxi-2-Pyrazineboxamide)。
T-1105攻击机器 病毒依赖它复制因为这些化学路径对产生更多病毒如此关键, 研究者假设抗病毒效果可能有效, 不论该抗病毒作用是什么压力
西和摩洛卡首次测试T-1105能力以防止FMD病毒复制动物细胞体外培养研究队想测试T-1105抗病毒能力 以尽量多口蹄疫为了实现这一点,他们共收集28FMDV菌株来源于2000年和2010年日本FMD暴发期间受感染的动物,以及与蒙古、泰国、加纳、缅甸、巴基斯坦和Pirbright研究所(WOAH/FAO世界参考实验室FMD,UK)相邻国家研究人员协作收集的其他菌株抗病毒复合物T-1105以低至对宿主动物细胞培养无毒的浓度添加

+T-1105主机细胞停止所有28株FMDV使用主机细胞生成更多病毒表示这种处理对病毒所有菌株都有效
从病毒工厂到病毒阻塞器
很明显 任何抗病毒治疗的真正测试 是要检验它是否对感染疾病的动物有效研究团队为达此目的向FMDV菌株之一接触猪并用T-1105处理猪 看它是否停止口蹄疫的正常发展
猪感染FMDV前或后立即接受T-1105治疗后,无一继而有任何口蹄疫症状更重要的是从疾病控制角度讲,从样本中找不到FMD病毒粒子,样本取自鼻鼻、脚或其他似然组织西和森冈的工作显示,我们现在可能有有效选择来阻止FMDV暴发这可能对减少动物痛苦产生相当大的效果,并可能改变受FMDV影响的国家间疾病预防经济学和贸易关系
单带药用餐时间可能足以保护农场动物实用可能性
多数人最近有第一手经验等待队列获取COVID-19或流感疫苗福利意义极大且合理的长期性,但也是一个代价高昂的过程,需要一批心甘情愿的接受者和培训医疗专业人员。

T-1105对FMDV的直接动作可能比疫苗短得多,但T-1105和类似产品的真正奖金之一是它足够稳定,可以口服并添加成猪饲料粉不需要针头 不需要队列幸运的是,T-1105粉状形式没有把猪从食物中解脱出来,所以一种配药用餐时间可能足以保护农家
研究队建议,T-1105可以喂养生活在FMDV突发事件检测区中的猪,作为对有直接感染危险的动物采取的重点预防措施。受感染数小时后提供治疗效果也不错,因此也可以快速应用到农场内所有其它动物中检测到FMDV案例研究者认为这个处理选项 是一种实用方法 有可能抑制 任何疾病暴发

风险阻抗
任何疾病处理中的一个关注点是它是否能长期继续有效研究团队通过向FMDV低剂量T-1105连续20次检测抗病毒处理是否随时间变弱效果来评估这一关注问题令人鼓舞的是,那些多次接触亚致命剂量T-1105的病毒群没有显示对治疗更具抗药性的迹象。
西桥和莫里奥卡研究团队正在获取的结果有望成为迈向未来的第一步,农夫可以开始驯服口蹄疫,而他们用来恐惧的毁灭性暴发将成为历史
西桥和莫里奥卡研究团队正在获取的结果有望成为迈向未来的第一步,农夫可以开始驯服口蹄疫,而他们用来恐惧的毁灭性暴发将成为历史
个人响应
T-1105还有效消除FMDV在其他类型牲畜中的感染吗?正在继续研究解答如果它可以应用到其他种类的牲畜中,这种抗病毒剂预防FMD暴发的潜力将进一步扩大
未来如何管理口蹄疫
为了控制牲畜疾病,必须确保可追踪性并遵守例行卫生管理。万一暴发,我们希望开发一种方法,通过应用抗病毒药剂和疫苗避免病毒传播,而不必依赖裁剪
并使用抗病毒药物?
对,我们有人用抗病毒动物安全也需要验证

